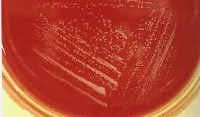

Другие названия и синонимы
Campylobacteriosis.
МКБ-10 коды
|
|
Описание
Кампилобактериоз - группа инфекционных болезней животных и человека, характеризующихся различной степенью тяжести и полиморфностью проявлений.
Краткие исторические сведения.
Впервые возбудители у больных диареями обнаружил Т. Эшерих (1884). Возможность их циркуляции в крови больного доказана Ж.Г. Венсаном (1947). Этиологическую значимость микроорганизмов в развитии энтеритов у людей отметила Э. Кинг.
С начала 80-х годов XX века отечественные и зарубежные исследователи обратили внимание на достаточно высокий уровень диарейных заболеваний населения, вызванных кампилобактерами (более 8%).
Краткие исторические сведения.
Впервые возбудители у больных диареями обнаружил Т. Эшерих (1884). Возможность их циркуляции в крови больного доказана Ж.Г. Венсаном (1947). Этиологическую значимость микроорганизмов в развитии энтеритов у людей отметила Э. Кинг.
С начала 80-х годов XX века отечественные и зарубежные исследователи обратили внимание на достаточно высокий уровень диарейных заболеваний населения, вызванных кампилобактерами (более 8%).
Клиническая картина
Гастроинтестинальная форма. Инкубационный период продолжается в среднем 2-5 дней. Приблизительно у половины больных в первые 2-3 дня болезни появляются неспецифические гриппоподобные симптомы: повышение температуры тела до 38 °С и более, ознобы, головная боль, боли в мышцах и суставах. Вскоре в клинической картине заболевания появляются черты, придающие ему характер гастрита, гастроэнтерита, гастроэнтероколита, энтероколита или колита.
В соответствии с вариантом течения клиническая картина заболевания может быть очень похожа на гастритический или гастроэнтеритический варианты пищевой токсикоинфекции или острую дизентерию. В таких случаях окончательный диагноз ставят только после его подтверждения бактериологическим исследованием.
Развитие энтероколита и колита особенно характерно для больных в Европе и, в частности, в Украине. На фоне общетоксических признаков или несколько позднее возникают боли в животе, локализованные главным образом в левой подвздошной области или носящие разлитой коликообразный характер. Интенсивность различна; иногда боли настолько выражены, что симулируют картину острого живота. Возможны тошнота и рвота. Стул обильный, жидкий, каловый, зловонный, зелёного цвета. Частота дефекаций варьирует от нескольких раз до 10 раз в сутки и более. Однако при развитии колитического варианта заболевания испражнения быстро становятся скудными, в них появляются слизь и прожилки крови, а примерно у половины больных испражнения приобретают вид «ректального плевка». Явления гемоколита более характерны для кампилобактериоза, вызванного С. jejuni. Тенезмы и ложные позывы появляются нечасто.
В редких случаях развиваются терминальный илеит и мезаденит. Через 1-3 нед после начала диареи могут возникнуть явления реактивного артрита или развиться пятнистая, пятнисто-папулёзная или уртикарная экзантема. Длительность заболевания варьирует от нескольких дней до 2 нед и более, возможны рецидивы.
Генерализованная форма. Основной возбудитель - С. fetus подвида fetus. Наиболее часто проявляется бактериемией, длительной лихорадкой, но без полиорганной диссеминации возбудителей и развития в органах микроабсцессов. К этому варианту инфекции наиболее восприимчивы беременные и дети младшего возраста.
Клиническая картина септикопиемии чаще развивается на фоне предшествующих заболеваний - цирроза печени, сахарного диабета, туберкулёза, злокачественных образований, лейкоза и , а также при иммуносупрессивных состояниях. Вторичные септические очаги могут формироваться в лёгких, печени, головном мозге, почках, миокарде, брюшине, формируя на фоне выраженной интоксикации проявления соответствующих клинических вариантов - менингитов и менингоэнцефалитов, миокардитов и эндокардитов, гепатитов, нефритов при общем тяжёлом состоянии больных. В этих случаях заболевание может осложнить развитие инфекционно-токсического шока.
Хроническая форма. По характеру развития напоминает хрониосепсис; проявляется вялым течением, субфебрилитетом, прогрессивным похуданием. Временами у больных появляются боли в животе, тошнота, рвота и жидкий стул. Течение заболевания могут сопровождать артриты, кератиты, конъюнктивиты, вагиниты и вульвовагиниты.
Субклиническая форма (бактерионосительство). Характерно выделение возбудителя с испражнениями при отсутствии клинических признаков заболевания, но с нарастанием титров специфических антител в крови. Длительность бактериовыделения в большинстве случаев не превышает 1 мес.
Ассоциированные симптомы: Боль внизу живота у женщин. Боль внизу живота у мужчин. Водянистый понос. Головная боль. Озноб. Отсутствие аппетита. Понос (диарея). Потливость. Рвота. Судороги. Тошнота.
В соответствии с вариантом течения клиническая картина заболевания может быть очень похожа на гастритический или гастроэнтеритический варианты пищевой токсикоинфекции или острую дизентерию. В таких случаях окончательный диагноз ставят только после его подтверждения бактериологическим исследованием.
Развитие энтероколита и колита особенно характерно для больных в Европе и, в частности, в Украине. На фоне общетоксических признаков или несколько позднее возникают боли в животе, локализованные главным образом в левой подвздошной области или носящие разлитой коликообразный характер. Интенсивность различна; иногда боли настолько выражены, что симулируют картину острого живота. Возможны тошнота и рвота. Стул обильный, жидкий, каловый, зловонный, зелёного цвета. Частота дефекаций варьирует от нескольких раз до 10 раз в сутки и более. Однако при развитии колитического варианта заболевания испражнения быстро становятся скудными, в них появляются слизь и прожилки крови, а примерно у половины больных испражнения приобретают вид «ректального плевка». Явления гемоколита более характерны для кампилобактериоза, вызванного С. jejuni. Тенезмы и ложные позывы появляются нечасто.
В редких случаях развиваются терминальный илеит и мезаденит. Через 1-3 нед после начала диареи могут возникнуть явления реактивного артрита или развиться пятнистая, пятнисто-папулёзная или уртикарная экзантема. Длительность заболевания варьирует от нескольких дней до 2 нед и более, возможны рецидивы.
Генерализованная форма. Основной возбудитель - С. fetus подвида fetus. Наиболее часто проявляется бактериемией, длительной лихорадкой, но без полиорганной диссеминации возбудителей и развития в органах микроабсцессов. К этому варианту инфекции наиболее восприимчивы беременные и дети младшего возраста.
Клиническая картина септикопиемии чаще развивается на фоне предшествующих заболеваний - цирроза печени, сахарного диабета, туберкулёза, злокачественных образований, лейкоза и , а также при иммуносупрессивных состояниях. Вторичные септические очаги могут формироваться в лёгких, печени, головном мозге, почках, миокарде, брюшине, формируя на фоне выраженной интоксикации проявления соответствующих клинических вариантов - менингитов и менингоэнцефалитов, миокардитов и эндокардитов, гепатитов, нефритов при общем тяжёлом состоянии больных. В этих случаях заболевание может осложнить развитие инфекционно-токсического шока.
Хроническая форма. По характеру развития напоминает хрониосепсис; проявляется вялым течением, субфебрилитетом, прогрессивным похуданием. Временами у больных появляются боли в животе, тошнота, рвота и жидкий стул. Течение заболевания могут сопровождать артриты, кератиты, конъюнктивиты, вагиниты и вульвовагиниты.
Субклиническая форма (бактерионосительство). Характерно выделение возбудителя с испражнениями при отсутствии клинических признаков заболевания, но с нарастанием титров специфических антител в крови. Длительность бактериовыделения в большинстве случаев не превышает 1 мес.
Ассоциированные симптомы: Боль внизу живота у женщин. Боль внизу живота у мужчин. Водянистый понос. Головная боль. Озноб. Отсутствие аппетита. Понос (диарея). Потливость. Рвота. Судороги. Тошнота.
Возможные осложнения
При тяжело протекающей генерализованной инфекции осложнения связаны с формированием абсцессов в различных органах и возможным развитием инфекционно-токсического шока.
Причины
Возбудители - микроаэрофильные грамотрицательные подвижные споронеобразующие бактерии рода сampylobacter семейства сampylobacteriaceae. В соответствии с последней классификацией, семейство сampylobacteriaceae включает 2 рода - сampylobacter и помимо него - Arcobacter. Кампилобактеры представлены спиральными (могут иметь один и более витков), S-образными или изогнутыми клетками. При культивировании более 48-72 ч образуют кокковидные формы. Бактерии прихотливы к условиям культивирования. Обычно их выращивают на средах с кровью, дополненных различными ингибиторами роста контаминирующей флоры. Оптимум рН - 6,2-8,7, температуры - 42 °С. Атмосфера культивирования должна содержать не менее 10-17% С02. Известно девять видов кампилобактеров, однако наибольшее значение в патологии человека имеют С. jejuni, С. coli, С. lari и С. fetus подвида fetus. Реже диареи у человека вызывают С. hyointestinalis, С. upsaliensis, С. sputorum подвида sputorum. Подавляющее большинство случаев кампилобактериоза у детей и взрослых вызывает С. jejuni. Большинство случаев генерализованных и септических форм внекишечного кампилобактериоза вызывает С. fetus подвида fetus. Из четырёх видов Arcobacter клиническое значение имеют A. cryaerophilus group 1 В и A. butzleri.
Кампилобактеры чувствительны к высушиванию, длительному воздействию прямого солнечного света. В пресной воде при температуре 4 °С выживают в течение нескольких недель, при 25 °С - 4 дня, в почве и помёте птиц - до 30 сут. При нагревании до 60 °С бактерии погибают через 1 мин; кипячение и хлорирование воды вызывает быструю их гибель. Кампилобактеры чувствительны к эритромицину, левомицетину, стрептомицину, канамицину, малочувствительны к пенициллину, устойчивы к сульфаниламидам и триметаприму.
Эпидемиология.
Резервуар и источник инфекции - дикие и сельскохозяйственные животные и птицы, у которых помимо болезни возможно и носительство. Роль диких животных и птиц в распространении инфекции менее значима, однако установлено, что частота заражения птиц достигает 25-40% у голубей, 45-83% - у грачей и 90% - у ворон. Естественными резервуарами возбудителя часто оказываются свиньи, крупный рогатый скот, куры. Наибольшую эпидемиологическую опасность представляют куры, крупный рогатый скот, свиньи и овцы, особенно бессимптомные бактерионосители. Животные и птицы - носители выделяют возбудителей в окружающую среду в течение длительного периода (несколько месяцев и даже лет). Роль больных людей и бактерионосителей менее значима. Длительность выделения кампилобактеров у человека составляет 2-3 нед, в редких случаях может достигать 3 мес.
Механизм передачи - фекально-оральный, основной путь передачи - пищевой (через мясные и молочные продукты, овощи, фрукты), с которым связано большинство групповых заболеваний и крупных вспышек. Наиболее часто пищевой путь передачи реализуется при употреблении в пищу недостаточно хорошо термически обработанных цыплят-бройлеров, а также свинины и продуктов её переработки (котлеты, студни ). Роль сырого молока в передаче возбудителя незначительна. Возможен бытовой путь передачи возбудителя, особенно при инфицировании новорождённых, беременных и пожилых. Заболевание может возникнуть при прямом контакте с больными животными в процессе ухода за ними во время отёлов и ягнения. Инфицирование наступает также при употреблении недостаточно термически обработанного мяса, заражённого прижизненно или при разделке. Большинство вспышек кампилобактериоза в США связано с употреблением пастеризованного молока. Несомненное значение имеет и водный путь передачи инфекции. Разные виды бактерий довольно часто выделяют из воды различных водоёмов. Инфицированные или больные женщины могут передавать кампилобактеров плоду трансплацентарно, при родах или в постнатальный период. Описаны случаи развития кампилобактериоза после переливания крови, гемодиализа. Среди животных кампилобактериоз передаётся половым, алиментарным и контактным путями.
Естественная восприимчивость людей высокая, о чём свидетельствует высокий уровень поражённости кампилобактериозом детей до 2 лет. Клиническая картина болезни может варьировать от бессимптомного носительства до тяжёлых поражений, что во многом определяет состояние резистентности макроорганизма и прежде всего иммунного статуса. Лица с иммунодефицитами составляют группу риска. Материнские антитела не подавляют колонизацию бактериями кишечника новорождённых. Характер и продолжительность постинфекционного иммунитета при кампилобактериозе недостаточно изучены. Очевидно, он носит типоспецифический характер.
Основные эпидемиологические признаки. Заболевание распространено повсеместно. Распространение кампилобактериоза вызвано интенсификацией животноводства, возросшей международной и национальной торговлей животными, кормами, продуктами животного происхождения. Кампилобактериоз составляет от 5 до 14% всех регистрируемых случаев кишечных инфекций.
Заболеваемость носит спорадический характер; чаще всего регистрируются семейные очаги кампилобактериоза. Особенностями эпидемического и эпизоотического процессов при кампилобактериозе являются увеличение циркуляции возбудителей среди кур и связанное с этим повышение значимости сельскохозяйственных птиц как источника инфекции для людей. В экономически развитых странах заражение инфекцией связано главным образом с инфицированным куриным мясом, в развивающихся странах - с водой. Заболевание регистрируют в течение всего года, с подъёмом заболеваемости в летне-осенние месяцы. Кампилобактерии нередко вызывают «диарею путешественников». Важными социальными факторами, влияющими на распространённость кампилобактериоза, являются санитарно-гигиенические условия жизни, национальные привычки и характер питания населения. Кампилобактериозом болеют люди всех возрастов, но наиболее часто дети от 1 года до 7 лет. Увеличивает риск инфицирования грудных детей ранний переход на искусственное вскармливание. Нозокомиальные случаи кампилобактериоза описаны среди новорождённых.
Кампилобактеры чувствительны к высушиванию, длительному воздействию прямого солнечного света. В пресной воде при температуре 4 °С выживают в течение нескольких недель, при 25 °С - 4 дня, в почве и помёте птиц - до 30 сут. При нагревании до 60 °С бактерии погибают через 1 мин; кипячение и хлорирование воды вызывает быструю их гибель. Кампилобактеры чувствительны к эритромицину, левомицетину, стрептомицину, канамицину, малочувствительны к пенициллину, устойчивы к сульфаниламидам и триметаприму.
Эпидемиология.
Резервуар и источник инфекции - дикие и сельскохозяйственные животные и птицы, у которых помимо болезни возможно и носительство. Роль диких животных и птиц в распространении инфекции менее значима, однако установлено, что частота заражения птиц достигает 25-40% у голубей, 45-83% - у грачей и 90% - у ворон. Естественными резервуарами возбудителя часто оказываются свиньи, крупный рогатый скот, куры. Наибольшую эпидемиологическую опасность представляют куры, крупный рогатый скот, свиньи и овцы, особенно бессимптомные бактерионосители. Животные и птицы - носители выделяют возбудителей в окружающую среду в течение длительного периода (несколько месяцев и даже лет). Роль больных людей и бактерионосителей менее значима. Длительность выделения кампилобактеров у человека составляет 2-3 нед, в редких случаях может достигать 3 мес.
Механизм передачи - фекально-оральный, основной путь передачи - пищевой (через мясные и молочные продукты, овощи, фрукты), с которым связано большинство групповых заболеваний и крупных вспышек. Наиболее часто пищевой путь передачи реализуется при употреблении в пищу недостаточно хорошо термически обработанных цыплят-бройлеров, а также свинины и продуктов её переработки (котлеты, студни ). Роль сырого молока в передаче возбудителя незначительна. Возможен бытовой путь передачи возбудителя, особенно при инфицировании новорождённых, беременных и пожилых. Заболевание может возникнуть при прямом контакте с больными животными в процессе ухода за ними во время отёлов и ягнения. Инфицирование наступает также при употреблении недостаточно термически обработанного мяса, заражённого прижизненно или при разделке. Большинство вспышек кампилобактериоза в США связано с употреблением пастеризованного молока. Несомненное значение имеет и водный путь передачи инфекции. Разные виды бактерий довольно часто выделяют из воды различных водоёмов. Инфицированные или больные женщины могут передавать кампилобактеров плоду трансплацентарно, при родах или в постнатальный период. Описаны случаи развития кампилобактериоза после переливания крови, гемодиализа. Среди животных кампилобактериоз передаётся половым, алиментарным и контактным путями.
Естественная восприимчивость людей высокая, о чём свидетельствует высокий уровень поражённости кампилобактериозом детей до 2 лет. Клиническая картина болезни может варьировать от бессимптомного носительства до тяжёлых поражений, что во многом определяет состояние резистентности макроорганизма и прежде всего иммунного статуса. Лица с иммунодефицитами составляют группу риска. Материнские антитела не подавляют колонизацию бактериями кишечника новорождённых. Характер и продолжительность постинфекционного иммунитета при кампилобактериозе недостаточно изучены. Очевидно, он носит типоспецифический характер.
Основные эпидемиологические признаки. Заболевание распространено повсеместно. Распространение кампилобактериоза вызвано интенсификацией животноводства, возросшей международной и национальной торговлей животными, кормами, продуктами животного происхождения. Кампилобактериоз составляет от 5 до 14% всех регистрируемых случаев кишечных инфекций.
Заболеваемость носит спорадический характер; чаще всего регистрируются семейные очаги кампилобактериоза. Особенностями эпидемического и эпизоотического процессов при кампилобактериозе являются увеличение циркуляции возбудителей среди кур и связанное с этим повышение значимости сельскохозяйственных птиц как источника инфекции для людей. В экономически развитых странах заражение инфекцией связано главным образом с инфицированным куриным мясом, в развивающихся странах - с водой. Заболевание регистрируют в течение всего года, с подъёмом заболеваемости в летне-осенние месяцы. Кампилобактерии нередко вызывают «диарею путешественников». Важными социальными факторами, влияющими на распространённость кампилобактериоза, являются санитарно-гигиенические условия жизни, национальные привычки и характер питания населения. Кампилобактериозом болеют люди всех возрастов, но наиболее часто дети от 1 года до 7 лет. Увеличивает риск инфицирования грудных детей ранний переход на искусственное вскармливание. Нозокомиальные случаи кампилобактериоза описаны среди новорождённых.
|
|
Лечение
Лечение при развитии гастроинтестинальной формы заболевания по типу гастроэнтерита или энтерита обычно ограничиваются назначением симптоматических средств; необходимость этиотропной терапии относительна, поскольку в таких случаях заболевание склонно к самоограничению. Этиотропное лечение назначают при колитическом варианте гастроинтестинальной формы, генерализованной и хронической формах кампилобактериоза, а также во всех случаях у больных с отягощенным преморбидным фоном. Этиотропная терапия включает назначение эритромицина по 500 мг 4 раза в день (детям - по 40 мг/кг/сут). Препараты резерва - фторхинолоны (ципрофлоксацин), препараты второго ряда - клиндамицин, гентамицин, доксициклин, а также фуразолидон (при колитическом варианте). Дозы этих препаратов зависят от возраста пациентов, курс лечения не менее 7 дней. В ряде случаев требуются повторные курсы этиотропных средств или смена препаратов при их малой клинической эффективности, что может быть связано с нарастающей резистентностью кампилобактеров к антибиотикам, в частности к эритромицину.